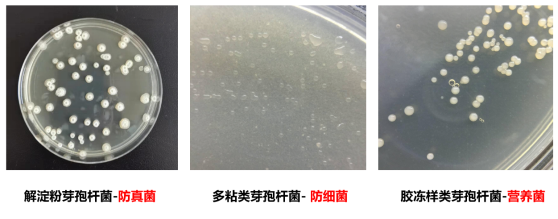
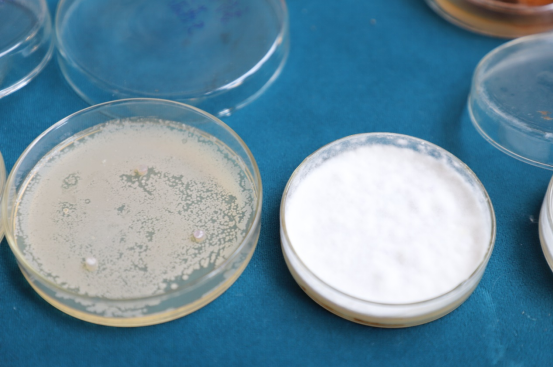

世科姆护根养根新添重磅选手!“护苗行动”再掀高潮……
农信传媒报道:近几年,许多种植户应该都深有感触,发现随着种植年限增长、重茬种植后,设施内蔬菜出现死苗烂棵的现象越来越多,尤其是黄瓜、西红柿、豆类等主要品种,都存在严重的死棵问题,让人焦头烂额,不胜其烦!
为何会出现这样的情况?如何才能解决问题?这恐怕是众多种植户迫切想得到答案的。4月27日,在莺飞草长,春和景明的山东潍坊,“世科姆护苗行动——护根养根论坛暨万重根®上市会”上,您或许能得到答案……

世科姆护苗行动——护根养根论坛暨万重根®上市会在山东潍坊举办
作物根部病害难防难治,维护土壤微生物生态系统的平衡是关键!
作物出现死苗烂棵的现象很多都是由于根部出现病害,而作物根部病害又是出了名的难防难治,初期不易发现,地上部分出现明显症状时,病害已进入晚期。而且由于根部病害的复杂性,侵染性根病与生理性根病极易混淆。更不要说现在越来越多的病原菌抗药性还在不断加强!

中国微生物协会会员、中国海洋大学生态毒理学博士、山东省应用真菌重点实验室成员、任教于青岛农业大学生命科学学院微生物系的陆秀华老师在本次会议上作报告
“土壤生态系统功能的失衡是作物根部病害频发的根本原因,因此维护土壤微生物生态系统的平衡对根部病害的防治至关重要。”在本次会议上,来自中国微生物协会会员、中国海洋大学生态毒理学博士、山东省应用真菌重点实验室成员、任教于青岛农业大学生命科学学院微生物系的陆秀华老师这样说到。因此陆老师认为,解铃还须系铃人,要利用有益微生物的共生菌群恢复微生态平衡防治病原菌的危害符合自然规律。

世科姆市场部产品经理杜加银在本次会议上作报告
“土壤微生物是退化土地恢复的变局者!”世科姆市场部产品经理杜加银指出,通过调节养分循环、分解有机质、改变土壤结构、抑制植物病害和促进植物生产力,微生物控制了土壤生命,并发挥一系列重要的土壤功能。单一微生物物种不太可能适应和生存在所有的土壤环境,微生物群落结构和多样性也可以作为土壤健康的指标。
世科姆药肥一体化方案的新成员万重根®,修复土壤的“一把好手”
既然土壤微生物如此重要,那么世科姆首款三菌合一微生物菌剂——万重根®的推出,如暗室逢灯,绝渡逢舟,从此修复土壤,俱可望有门径矣。
为何万重根®有如此功效?
陆秀华老师介绍说,万重根®的功能原理依据“君臣佐使”原理,菌种科学配伍:
“君”为解淀粉芽孢杆菌,主治真菌性病害,繁殖速度快,占位能力强,补充根际优势菌群;
“臣”为多粘类芽孢杆菌,主治细菌性病害,形成生物膜能力强,为根系健康生长保驾护航;
“佐”为胶冻样类芽孢杆菌,活化土壤养分,促进作物增产提质;
“使”为丰富的微生物代谢产物,含氨基酸、植物生长调节物质,调控作物健康生长。
万重根®的优势特点又有哪些?杜加银经理介绍说:
三菌合一
优选解淀粉芽孢杆菌KN-527、多粘类芽孢杆菌KN-03、胶冻样类芽孢杆菌,三菌强强联合。万重根®拥有专利菌株、科学配伍,三种土壤核心菌种可快速构建和平衡土壤微生物菌落。
防病护根
能攻,占位能力强,快速补充根际优势菌群。能守,分泌抑菌物质,防控细菌、真菌病害。此外,在根际形成生物膜,全方位保护根系,微生物代谢产物丰富,促进根系生长。
左边使用了万重根®,海棠枯萎病镰刀菌得到抑制;右边没有使用万重根®,海棠枯萎病镰刀菌长满培养皿
混配性强
芽孢耐性强,可以与多种杀菌剂混用,减轻抗药性。

万重根®与不同杀菌剂混配性
作为世科姆药肥一体化方案的新成员,万重根®担当修复土壤的重任,就像陆老师说的那样,解铃还须系铃人,万重根®通过恢复微生态平衡来防治病原菌,成效卓越。

微生物菌剂万重根®

超量的化肥使用带来严重的土壤问题,腐植酸等有机肥将成未来趋势

美国密歇根州立大学遗传与生物工程专业博士、青岛农业大学生命科学学院马倩副教授在本次会议上作报告
“中国用世界上9%的耕地养活了21%的人口,消耗了世界35%的化肥!中国普通化肥的使用量是远超世界其他国家的,这种大规模的使用,也给我们的土壤造成了很大的问题,如土壤酸化板结、重金属污染等,因此有机肥的使用也越来越受到重视!”在本次会议上,美国密歇根州立大学遗传与生物工程专业博士、青岛农业大学生命科学学院马倩副教授这样说起。
作为有机肥的一种,自从1786年人类从土壤中首次得到腐植酸后,腐殖酸为我们的农业生产提供了巨大的帮助。它可以刺激作物生长;为肥料增效;改良土壤,促进土壤益生菌的繁殖;提高果树的品质,增加果实口感;提高药效、抑制残毒;促进作物抵御非生物胁迫;促进植物抵御生物胁迫。
世科姆此次推出的高浓度腐植酸水溶肥料——诺青®,源自美国北达科他州加斯科因地区风化褐煤矿,拥有高含量的腐植酸(以干基计≥65%),该煤矿被公认为是世界上最好的风化褐煤矿藏,还拥有天然的氮、铜、锌等营养元素,杂质少, 重金属含量低等优点。诺青®通过高精细化设备物理研磨;组分全,包含黄腐酸、棕腐酸、黑腐酸、胡敏素;含量高(150g/L)、pH5-6活性高等多重优势。诺青®搭配水溶肥使用,还可以增加肥料吸收利用率,达到“1+1>2”的功效。

含腐殖酸水溶肥料诺青®
三年来“护苗行动”一直在行动,为各地作物生长保驾护航

当作物遇到有问题的土壤,各种病虫害层出不穷(死棵,烂苗,线虫,根肿等等),使得生产成本增加,管理难度加大,农作物产量品质下降,甚至减产绝收。

世科姆市场部经理张磊对“护苗行动”进行了介绍
据世科姆市场部经理张磊介绍,世科姆(中国)于2021年4月最早提出“护苗行动”,“护苗行动”是将世科姆的土壤病害防治产品与土壤改良修复产品,有针对性的组合成一系列作物解决方案,通过沾根、灌根、滴灌等措施施用,保护和调节作物根周生长环境,让作物健康生长,从而达到作物的增产、提质,让种植户少投入,省劲又赚钱。开展的三年以来,世科姆已在全国多地组织实施“护苗行动”,为各地作物生长保驾护航。

此次世科姆推出的新产品无论是万重根®、诺青®,还是即将推出的杀线虫剂棚帅®,作为“护苗行动”的新生力量,将使本就拥有完善的植保产品线和特种肥产品线的世科姆药肥一体化方案更具差异化优势。从播种到成熟,植物保护+植物营养,世科姆已经走在前列!

世科姆华北区经理贺少飞主持了本次会议,并介绍了世科姆助剂,演示了产品效果。

世科姆山东销售团队和当地的经销商、种植户现身说法“护苗行动”的优异效果。

在会议最后,还举行了万重根®战略合伙人签约仪式。

游客可直接评论,建议先注册为会员后评论!
以上评论仅代表会员个人观点,不代表中国农药网观点!



